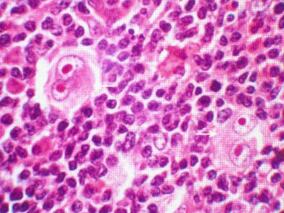
DLBCL和霍奇金淋巴瘤的最佳挽救疗法方案是GDP?

-
哪类患者可从前列腺癌术后化疗中获益?
环球医学资讯
 2017年01月23日
2017年01月23日 点击量:468
点击量:468 1小时条评论
1小时条评论手术是治疗早期前列腺癌患者的有效方法,但是依然不能保证完全控制病情。2016年11月,发表在《Lancet Oncol》的一项匹配、回顾性分析考察了前列腺癌的术后放疗应答的24位点基因预测的开发和验证。 背景:术后放疗对前列腺癌治疗有重要作用,个体化患者选择可能改善...
-
探索非小细胞肺癌化疗有效性的预测因子任重而道远
环球医学资讯
 2017年01月23日
2017年01月23日 点击量:400
点击量:400 1小时条评论
1小时条评论非小细胞肺癌(NSCLC)的治疗包括手术、放疗、化疗及分子靶向治疗等。2016年11月,发表在《Ann Oncol》的一项综述考察了NSCLC化疗有效性的预测因子。 背景:几十年来,传统的细胞毒性化疗(CCC)是NSCLC治疗的主力,也一直是治疗的关键。与平行于药物开发阶段(同伴...
-
他莫昔芬对乳腺癌存活者生育能力有何影响?
环球医学资讯
 2017年01月23日
2017年01月23日 点击量:621
点击量:621 1小时条评论
1小时条评论有研究表明,使用他莫昔芬会增加卵巢早衰的风险。2017年1月,发表在《Fertil Steril》的一项在美国开展的研究考察了他莫昔芬对乳腺癌存活者生育能力的影响。 目的:旨在使用深化理解成年女性癌症、健康和生存研究(FUCHSIA)中的数据,确定他莫昔芬是否与卵巢储备功...
-
局部晚期鼻咽癌:同步放化疗or联合诱导化疗?
环球医学资讯
 2017年01月23日
2017年01月23日 点击量:567
点击量:567 1小时条评论
1小时条评论2016年11月,发表在《Lancet Oncol》的一项III期、多中心、随机对照试验,对同步放化疗和联合诱导化疗治疗局部晚期鼻咽癌进行了比较。 背景:同步放化疗基础上添加顺铂、氟尿嘧啶和多西紫杉醇(TPF)诱导化疗治疗局部晚期鼻咽癌的价值不明确。研究者在一项适当的动...
-
替莫唑胺化疗vs放疗对低分级胶质瘤患者HRQOL的影响
环球医学资讯
 2017年01月23日
2017年01月23日 点击量:450
点击量:450 1小时条评论
1小时条评论2016年11月,发表在《Lancet Oncol》的一项由荷兰、比利时、加拿大等国科学家进行的随机、开放标签、3期组间研究,考察了高风险的低分级胶质瘤患者的健康相关生活质量(EORTC 22033-26033)。 背景:虽然高风险的低分级神经胶质瘤患者的替莫唑胺化疗和放疗之间的无...
-
低分级胶质瘤高风险患者:替莫唑胺化疗还是放疗?
环球医学资讯
 2017年01月22日
2017年01月22日 点击量:581
点击量:581 1小时条评论
1小时条评论目前,低级别胶质瘤(LGG)患者如何获得最佳的治疗方案仍然存在争议。2016年11月,发表在《Lancet Oncol》的一项随机、开放标签、三期临床试验调查了低分级胶质瘤高风险患者替莫唑胺化疗vs放疗的疗效。 背景:低分级胶质瘤的结局(WHO II级)差异较大,反映出疾病的...
-
肿瘤临床研究中的统计学争议:需要改变肿瘤进展时间…
环球医学资讯
 2017年01月22日
2017年01月22日 点击量:383
点击量:383 1小时条评论
1小时条评论肿瘤进展时间(TTP)是临床2期试验中常用的一个主要的终点指标。由于实际的最低点和进展期的日期未知,大部分计算得出的TTP都存在过高估计的问题。2016年11月,发表在《Ann Oncol.》的一项研究在2个假设的肿瘤动力环境和各种评估表中评价了这种不精确性对TTP估算的影...
-
肾切除术后高风险肾细胞癌患者辅助舒尼替尼治疗安全…
环球医学资讯
 2017年01月20日
2017年01月20日 点击量:324
点击量:324 1小时条评论
1小时条评论2016年12月,发表在《N Engl J Med》的一项由法、美、德国等国科学家进行的研究考察了肾切除术后高风险肾细胞癌患者辅助舒尼替尼治疗的安全性和有效性。 背景:舒尼替尼是一种血管内皮生长因子通路抑制剂,可有效治疗转移性肾细胞癌。本研究旨在确定舒尼替尼在肾切...
-
血液恶性肿瘤患者静脉注射泊沙康唑预防或治疗IFD是…
环球医学资讯
 2017年01月19日
2017年01月19日 点击量:370
点击量:370 1小时条评论
1小时条评论泊沙康唑注射液、缓释片和口服混悬液用于预防侵袭性曲霉属真菌感染,适用于因免疫系统严重受损的患者,免疫系统严重受损包括造血干细胞移植(HSCT)接受者患有的移植物抗宿主病(GVHD)或恶性血液病患者因化疗而导致长期的中性粒细胞减少。2016年12月,发表在《J Ant...
-
DLBCL和霍奇金淋巴瘤的最佳挽救疗法方案是GDP?
环球医学资讯
 2017年01月13日
2017年01月13日 点击量:250
点击量:250 1小时条评论
1小时条评论复发/难治性弥漫大B细胞淋巴瘤(DLBCL)或霍奇金淋巴瘤(HL)挽救疗法的最佳选择仍不清楚。2017年2月,发表在《Leuk Lymphoma》的一项研究显示,吉西他滨、地塞米松和顺铂(GDP)是复发/难治性DLBCL和HL门诊患者一种有效且耐受性良好的挽救方案。 复发/难治性弥漫大...

会员登录
会员登录

